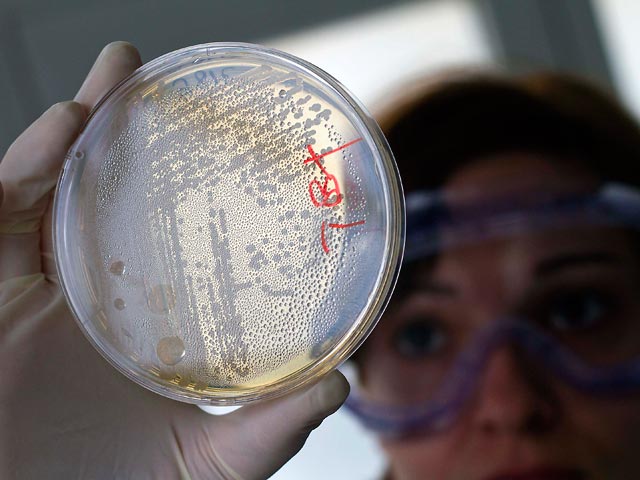

Россия оказалась права, не доверяя Европе: источник опасной бактерии-мутанта так и не нашли
В поисках источника охватившей Европу кишечной инфекции эксперты рискуют вновь оказаться в тупике, а Россия, постоянно подвергающая сомнению их выводы, может оказаться права. Похоже, все идет к тому, что версия о заразе на ферме в Биненбюттеле около города Ильцен на севере Германии не получит подтверждения. Экспертиза грозит затянуться, в то время как число заболевших приближается к трем тысячам человек, а число жертв возросло до 23 человек - еще одну смерть зафиксировали в Германии.
Предварительные анализы не выявили опасного штамма энтерогеморрагической кишечной палочки в ростках сои с этой фермы - анализ 23 из 40 образцов дал отрицательный результат. Кроме того, немецкие специалисты рассмотрели 500 проб овощей, но положительного результата не дал ни один образец, сообщают СМИ.
- Россия получит из Европы смертельную бактерию-мутанта - для изучения
- В МИДе рассказали, когда снимут запрет на овощи из Европы
В понедельник эпидемиологи начали анализ образцов ростков семян, но местные власти не исключают, что и эта проверка не даст результатов, так как все потенциально зараженные образцы могут быть уже распроданы. Тем не менее министр здравоохранения Германии Даниэль Бар заявил, что "есть ясные указания на то, что предприятие в Ильцене однозначно является источником инфекции, но нужно дождаться подтверждения этого лабораторной экспертизой", пишет "Коммерсант".
Министр сельского хозяйства Ильзе Айгнер, со своей стороны, предостерегла население от употребления в пищу ростков сои, помидоров, салата и огурцов, пока не будет обнаружен источник инфекции, оказавшейся одной из самых опасных в истории страны. При этом она выступила в защиту правительства, которое критикуют за неспособность найти и взять под контроль источник вспышки, сообщает The Wall Street Journal.
Гипотезы и слухи: "виноваты" мясо, биореакторы и даже террористы
На фоне драматического развития ситуации гипотезы множатся. Reuters сообщает, что подозрения распространились не только на овощи, но и на мясо. В частности, Чехия начала экспертизу говядины и свинины, экспортируемых из Германии. Тесты 30 образцов должны быть завершены к концу недели, передает "Газета.Ru".
Под подозрение, среди прочего, попали реакторы, вырабатывающие из отходов так называемый биогаз. Дискуссии о том, что содержимое биореакторов может быть рассадником возбудителей инфекций, ведутся уже не первый год, рассказывает Frankfurter Allgemeine Zeitung.
Издание цитирует Бернда Шоттдорфа, основателя крупнейшей в Европе частной медицинской лаборатории Schottdorf MVZ, который говорит, что в биореакторах "бактерии сплавляются воедино и доподлинно не изучено, что там происходит на самом деле". И эта биомасса впоследствии используется в качестве удобрений.
Дискуссии по поводу безопасности использования биогаза уже разгорались в прошлом, говорится в статье. В свое время эти установки заподозрили в распространении бактерии Clostridium botulinum, производящей опасные для человека и животного токсины ботулизма. Однако тогда установить прямую связь между эксплуатацией биореакторов и распространением вредоносного штамма не удалось.
Союз немецких производителей биогаза считает и нынешние подозрения беспочвенными, аргументируя свою позицию тем, что биомасса в течение часа прогревается при температуре 70 градусов по Цельсию.
В целом, пишет автор публикации, не вдаваясь в подробности, неопределенность с источником смертельно опасной инфекции породила даже слухи о террористическом происхождении бактерии. Материалы зарубежных изданий по теме изучил сайт InoPressa.
Россия получит из Европы смертельную бактерию-мутанта - для изучения
Ситуация с заболеванием неизвестного происхождения едва не рассорила Евросоюз с Россией, которая запретила импорт его овощей на свои рынки. В Европе эту меру расценили как непропорциональную угрозе и предупредили, что это может создать стране проблемы со Всемирной торговой организацией, куда она стремится вступить.
Во вторник глава Роспотребнадзора, главный санитарный врач РФ Геннадий Онищенко встретился в Москве с представителями генерального директората по здравоохранению и защите потребителей Европейской комиссии. На ней было обещано, что штамм опасной бактерии будет передан России для исследования, передает "Интерфакс".
Онищенко оценил встречу позитивно, отметив, что "произошло сближение позиций", хотя к властям ЕС появились новые вопросы после того, как к списку стран, где зафиксирована кишечная инфекция, присоединился Люксембург.
Накануне глава Роспотребнадзора сказал, что служба пока не удовлетворена ответом из ЕС по поводу безопасности овощной продукции. Но он похвалил позицию властей Дании, которые вступили с российскими властями в диалог. Во вторник по итогам встречи он добавил, что, если Дания даст дополнительные данные, запрет на ее овощи может быть снят.
На прошлой неделе Онищенко назвал четыре условия, на которых Россия может отменить запрет на европейские овощи. Власти ЕС должны:
- установить возбудителя и причину инфекции;
- определить, каким путем передается заболевание;
- назвать место происхождения зараженных продуктов;
- объективно подтвердить, что ситуация взята под контроль, и рост числа заболевших прекращен.
В МИДе рассказали, когда снимут запрет на овощи из Европы
Комментарий на тему поступил во вторник из МИДа в Москве. Замглавы ведомства Александр Грушко заявил в интервью "Интерфаксу", что Россия снимет запрет на ввоз овощей из Европы, как только получит на руки убедительные разъяснения и гарантии безопасности.
"Евросоюзу будет разрешено вновь ввозить овощную продукцию в Россию, как только Брюссель предоставит нам надежные и проверяемые гарантии безопасности продукции. Мы рассчитываем, что вопрос будет решен на уровне соответствующих служб. Но на сегодня достаточно убедительных разъяснений нет", - цитирует его агентство.
Отвечая на вопрос, удастся ли урегулировать "овощной вопрос" до саммита РФ-ЕС в Нижнем Новгороде 9-10 июня, Грушко сказал: "Это зависит от поворотливости структуры Евросоюза". "Вчера ЕС продвинулся в понимании того, что могло служить причиной вспышки заболевания. Еще раз подчеркну, что если российская сторона получит все необходимые гарантии, вопрос будет закрыт", - сказал он.
"Эмоций много, но на самом деле специалисты понимают, о чем идет речь. И как только будет ясна причина, по которой в Западной Европе произошла эпидемия, можно будет двигаться вперед в направлении снятия соответствующих ограничений", - заключил замминистра.
Симптомы и возбудитель болезни
Напомним, власти Германии в конце мая забили тревогу в связи с распространением смертельно опасной кишечной инфекции, которую вызывает энтерогеморрагическая кишечная палочка - опасный штамм этой известной бактерии. У человека болезнь протекает в форме гемолитико-уремического синдрома, который характеризуется геморрагической диареей, острой почечной недостаточностью и анемией и может привести к смерти.
Всемирная организация здравоохранения заявила, что штамм, о котором идет речь, является принципиально новым микроорганизмом, с которым медицина ранее не сталкивалась. Как там пояснили, это мутировавшая форма двух различных бактерий кишечной палочки, и именно этим объясняется столь стремительное распространение инфекции среди жителей европейских стран, а также ее опасность для жизни человека.
Ученые из университетской клиники Гамбурга совместно с китайскими коллегами расшифровали геном этого штамма бактерии и пояснили, что она представляет собой многоклеточный организм, совмещающий в себе свойства двух возбудителей болезни. На 80% она состоит из привычного штамма кишечной палочки и на 20% - из штамма более опасной и токсичной бактерии.
Источником заразы изначально сочли огурцы из Испании, но они были реабилитированы.